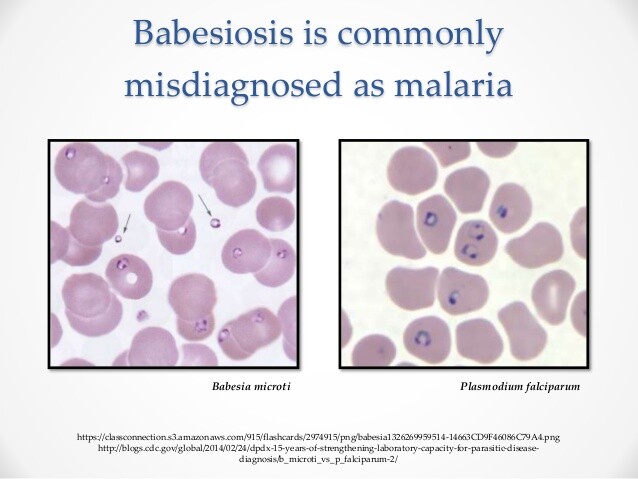
Babésiose

Paludisme et babésiose
PLASMODIUM SPP.
- Antécédents d'exposition, tels qu'un voyage, une transfusion récente ou une résidence à proximité immédiate d'un aéroport international.
- Paludisme non falciparum : frissons et pics fébriles, suivis d'une défervescence et d'une fatigue ; les symptômes peuvent être cycliques toutes les 48-72 heures.
- Paludisme à P. falciparum : pics fébriles et frissons, souvent non cycliques, associés à une évolution systémique rapide.
- Détection et identification d'une espèce de Plasmodium sur un frottis sanguin épais et un frottis sanguin mince, respectivement.
- Détection moléculaire de la protéine riche en histidine de P. falciparum par dosage immuno-enzymatique (ELISA), ou de l'ADN de Plasmodium par réaction en chaîne par polymérase (PCR), suivie d'une détermination de l'espèce par hybridation de sondes ou par séquençage de l'ADN.
Ces éléments soulignent la complémentarité entre les antécédents d'exposition, les profils cliniques de fièvre et les examens de laboratoire pour étayer le diagnostic de paludisme. Une reconnaissance rapide est importante, car certaines formes, en particulier celles dues à P. falciparum, peuvent évoluer rapidement et engager le pronostic vital chez les personnes non immunisées.
Considérations générales
Épidémiologie
Le paludisme, maladie ancienne, a été reconnu par Hippocrate et a été décrit, peut-être dès 1700 av. J.-C., dans des textes chinois anciens. Le paludisme est une maladie mondiale qui survient le plus souvent sous les tropiques ; toutefois, la transmission peut également se produire en zones tempérées. Aux XIXe et au début du XXe siècle, les espèces de Plasmodium étaient largement réparties aux États-Unis. Cette répartition incluait le sud des États-Unis, la vallée du Mississippi et des extensions jusqu'au Minnesota et au Michigan.
Aujourd'hui, principalement dans les zones tropicales, les parasites du genre Plasmodium continuent de provoquer plus de 100 millions de cas de paludisme par an. Cela entraîne environ 1 à 2 millions de décès annuels, dont beaucoup surviennent chez des enfants. En réalité, plus de 90 % des paludismes graves et potentiellement mortels surviennent chez les enfants. La répartition des moustiques vecteurs et la prévalence de la maladie dans les populations indigènes constituent les principaux facteurs qui déterminent la distribution du parasite Plasmodium.
Les zones infestées de moustiques, telles que les marais, ont longtemps été associées à des taux d'attaque élevés du paludisme. Les environnements qui favorisent la présence durable d'eau stagnante facilitent la reproduction des moustiques. Actuellement, les zones endémiques comprennent des parties des Caraïbes, le nord de l'Amérique du Sud, l'Amérique centrale, des parties de l'Afrique, l'Inde, des parties de l'Australie, l'Asie du Sud-Est et de nombreuses îles de l'Asie-Pacifique.
Le paludisme survient également de manière sporadique en zones non endémiques. Dans de nombreux cas, il s'agit d'une maladie importée, latente. Des rechutes palustres peuvent se manifester des mois après le retour de voyageurs provenant de zones endémiques. Ces patients ont généralement été traités de manière incomplète ou ont pris une chimioprophylaxie insuffisante.
Le paludisme récurrent est causé par la réactivation de la phase latente hépatique, dite hypnozoïte, de P. vivax ou P. ovale. Le paludisme peut être traité par une grande variété d'agents. Les antipaludéens les plus couramment utilisés, la chloroquine et la méfloquine, sont efficaces contre la phase érythrocytaire symptomatique de P. vivax et P. ovale et peuvent entraîner des guérisons apparentes. Ces médicaments sont toutefois inefficaces contre les hypnozoïtes hépatiques. Les patients traités de cette manière reçoivent donc un traitement incomplet et restent à risque de rechute palustre.
Certaines personnes peuvent rapporter n'avoir jamais eu d'épisode antérieur de paludisme. Un interrogatoire ciblé met toutefois souvent en évidence une brève interruption de la chimioprophylaxie. Une interruption de la chimioprophylaxie peut entraîner une période fenêtre avec des concentrations médicamenteuses subprophylactiques. Pendant cette période, des sporozoïtes injectés par un moustique infecté lors d'un repas sanguin peuvent atteindre et infecter le foie. Les parasites (mérozoïtes) qui émergent du foie pendant que le patient reprend la chimioprophylaxie sont rapidement éliminés, et le patient reste asymptomatique. Les hypnozoïtes peuvent toutefois se réactiver des mois après le retour d'une zone endémique, bien après l'arrêt de la chimioprophylaxie. L'identification correcte de P. vivax et P. ovale est importante, car seules ces espèces forment des hypnozoïtes hépatiques et peuvent entraîner une rechute palustre.
Dans les zones non endémiques, des cas de ce que l'on appelle le " paludisme d'aéroport " peuvent survenir. Des moustiques vecteurs provenant de zones endémiques peuvent être transportés avec le fret aérien. Une personne vivant près d'un aéroport en zone non endémique peut être infectée si elle est piquée par ces moustiques. La propagation du parasite n'est généralement pas durable dans l'environnement. Cela est dû soit à l'absence d'un moustique hôte approprié, soit au faible nombre de parasites dans la communauté. Lorsque la prévalence du paludisme est faible, la probabilité qu'un moustique ingère des gamétocytes est très faible. De plus, si les moustiques infectés sont rares, ils peuvent prendre un repas sanguin non humain, interrompant ainsi le cycle parasitaire.
La transmission par moustique est la voie d'infection la plus courante, mais d'autres modes de transmission existent. La transmission peut résulter de l'usage intraveineux de drogues (partage d'aiguilles) ou d'une transfusion sanguine. Dans ces cas, seul le cycle érythrocytaire s'établit, car les hépatocytes ne peuvent être infectés que par la forme sporozoïte du parasite.
Microbiologie
De nombreuses espèces de Plasmodium existent ; toutefois, seules quatre espèces sont connues pour infecter l'homme. Ces espèces sont P. falciparum, P. vivax, P. ovale et P. malariae. Dans le monde, P. vivax est responsable de la grande majorité des cas (environ 80 %), suivi de P. falciparum (environ 15 %).
Selon l'espèce plasmodiale en cause, le paludisme diffère en termes de gravité, de complications, de pronostic et de traitement. Il est donc important, à l'exception de la différenciation entre P. vivax et P. ovale, de préciser rapidement et correctement l'agent en cause. Le paludisme est généralement classé en deux types : falciparum et non falciparum. Cette distinction met en évidence la gravité du paludisme à P. falciparum, qui constitue une urgence médicale chez la personne non immunisée. Parmi les espèces non falciparum, il est important de distinguer P. vivax et P. ovale de P. malariae. Les deux premières espèces ont un stade hépatique dormant, qui nécessite un traitement spécifique afin d'éviter la rechute palustre.
L'identification des parasites Plasmodium et la différenciation des espèces reposent principalement sur la morphologie parasitaire dans des préparations sanguines colorées au Giemsa. La détection du parasite constitue la première étape du diagnostic de laboratoire du paludisme. Elle repose sur l'examen d'une préparation sanguine épaisse. L'examen d'une préparation épaisse est un élément important de la recherche de parasites dans le sang et ne doit pas être négligé, sauf si des plasmodies ont déjà été détectées sur un frottis sanguin périphérique de routine. La préparation épaisse augmente le rendement diagnostique par rapport à l'examen des frottis sanguins minces. Dans la préparation épaisse, un volume de sang plus important peut être examiné plus rapidement. Cela est essentiel pour détecter une parasitémie de faible intensité, comme celle associée aux infections prolongées par P. malariae ou au début d'un paludisme.
Les préparations épaisses sont réalisées en déposant 1-2 gouttes de sang du patient ensemble sur une lame de verre. Le sang n'est pas étalé et est laissé sécher à l'air. La lame est ensuite colorée selon la méthode de Giemsa, sans fixation au méthanol. Les érythrocytes non fixés (hématies) se lysent dans la solution colorante hypotonique. La préparation colorée est d'abord examinée avec un objectif 10x, puis en immersion à l'huile avec un objectif 100x.
La filariose est endémique dans de nombreuses régions où circulent les parasites du paludisme et peut provoquer des fièvres cycliques. Les microfilaires sont facilement détectées dans les préparations épaisses à 10x. L'objectif de l'examen en immersion à l'huile à 100x est de détecter les espèces de Plasmodium.
Dans les préparations colorées au Giemsa, les parasites de Plasmodium présentent une chromatine rouge et un cytoplasme bleu clair. Les formes annulaires de toutes les espèces de Plasmodium et les gamétocytes de P. falciparum sont les structures les plus facilement identifiables dans les préparations épaisses. Une pratique est nécessaire pour différencier les formes amiboïdes et les schizontes de Plasmodium des plaquettes et des débris. Les frottis minces doivent être examinés si les préparations épaisses démontrent la présence d'une espèce de Plasmodium.
Le frottis sanguin mince, fixé au méthanol et coloré au Giemsa, est utilisé pour la détermination de l'espèce de Plasmodium. Des critères utiles à la différenciation des espèces de Plasmodium sont résumés dans le Tableau 1. Toutefois, il est rare que toutes ces caractéristiques morphologiques soient présentes sur un frottis sanguin. La différenciation doit être réalisée à partir de l'ensemble des informations disponibles. Les critères morphologiques utiles à la différenciation des espèces de Plasmodium sont brièvement présentés ci-dessous.
Le gamétocyte en forme de croissant est pathognomonique de P. falciparum, mais cette structure n'est malheureusement pas toujours présente. Les caractéristiques du frottis périphérique qui, en association, peuvent être utilisées pour identifier P. falciparum comprennent la présence de petits trophozoïtes annulaires d'aspect délicat, le caractère normocytaire des érythrocytes infectés et la présence principalement de trophozoïtes annulaires, avec une absence marquée ou une rareté relative des formes plus avancées. Une parasitémie élevée et des érythrocytes infectés par plusieurs organismes sont plus souvent observés chez les patients atteints de paludisme falciparum. Les formes en applique et la présence de deux centres de chromatine par trophozoïte annulaire suggèrent également P. falciparum, mais peuvent être observées avec d'autres espèces de Plasmodium.
Contrairement à P. falciparum, P. vivax et P. ovale produisent des trophozoïtes annulaires plus épais et plus larges ; les hématies infectées deviennent macrocytaires, et des formes avancées, telles que les trophozoïtes amiboïdes, les schizontes, ou les deux, sont généralement présentes sur le frottis périphérique. Avec une coloration Giemsa correctement équilibrée en pH (pH 6,8-7,0), les hématies infectées par P. vivax ou P. ovale peuvent présenter une fine granulation éosinophile. Cette fine granulation ne doit pas être confondue avec des points plus gros et grossiers en forme de virgule (points de Maurer) qui peuvent être présents dans les érythrocytes infectés par P. falciparum. Les formes en applique sont généralement absentes dans les érythrocytes infectés par P. vivax ou P. ovale, et les trophozoïtes annulaires présentent le plus souvent un seul point de chromatine. Occasionnellement, plus d'un trophozoïte peut être présent par érythrocyte. Bien que P. vivax et P. ovale puissent être différenciés, cela est difficile et nécessite une expertise en parasitologie. La différenciation de P. vivax et P. ovale n'est généralement ni indiquée ni réalisée, car la maladie produite par ces organismes est similaire et le traitement est identique.
Les érythrocytes infectés par P. malariae contiennent invariablement certaines formes plasmodiales avancées et, comme P. vivax et P. ovale, les formes annulaires produites sont épaisses. En revanche, aucune granulation n'est observée. Des formes avancées spécialisées, telles que la forme en bande et la forme en panier, sont fortement évocatrices de P. malariae. Comme pour P. falciparum, les trophozoïtes annulaires peuvent occasionnellement contenir deux points de chromatine, et les érythrocytes infectés restent normocytaires.
Il convient de noter qu'il peut exister des co-infections par plusieurs espèces de Plasmodium. Les co-infections, en particulier chez les personnes vivant dans des zones endémiques pour plus d'une espèce de Plasmodium, sont relativement fréquentes. Il est important de détecter ces infections mixtes en raison des différences de pronostic et de prise en charge thérapeutique.
Pathogenèse
L'hôte définitif et le vecteur du parasite Plasmodium sont la femelle du moustique Anopheles. La reproduction asexuée et la gamétogenèse ont lieu chez l'hôte intermédiaire humain. Le cycle parasitaire est similaire pour toutes les espèces de Plasmodium. Toutefois, des différences importantes existent.
Les sporozoïtes infectieux proviennent des glandes salivaires de la femelle du moustique Anopheles. Ils sont transmis à l'homme lors d'un repas sanguin. Les sporozoïtes migrent ensuite via la circulation sanguine vers le foie, où les hépatocytes sont infectés. Dans le foie, des schizontes tissulaires se forment. Ceux-ci contiennent de nombreux mérozoïtes issus de la reproduction asexuée. À partir d'un seul sporozoïte, cette phase de reproduction asexuée entraîne une amplification de l'organisme de 10 000 à 30 000 fois. Cette partie du cycle de reproduction asexuée est commune à toutes les espèces de Plasmodium.
La production d'hypnozoïtes hépatiques dormants est spécifique au cycle de vie de P. vivax et P. ovale. Les hypnozoïtes hépatiques peuvent représenter une forme d'adaptation du parasite au climat. Dans les zones tempérées, cela permettrait au parasite palustre de " passer l'hiver " chez l'hôte humain. Cette stratégie serait avantageuse lorsque les conditions climatiques limitent l'activité du moustique vecteur. Après une période de dormance de 6 à 12 mois, les hypnozoïtes deviennent actifs et produisent des schizontes tissulaires.
À maturité, les schizontes tissulaires se rompent, et les mérozoïtes sont libérés dans la circulation sanguine. Les mérozoïtes infectent ensuite les hématies, où se déroule la deuxième phase de reproduction asexuée. La réplication asexuée intra-érythrocytaire est également commune à toutes les espèces de Plasmodium. P. falciparum et P. malariae peuvent envahir les érythrocytes de tout âge, tandis que P. vivax et P. ovale parasitent sélectivement uniquement les jeunes hématies. Les jeunes hématies conservent encore leur complément complet de membrane cytoplasmique et se dilatent avec la croissance de l'organisme. Les hématies plus âgées, infectées par P. falciparum ou P. malariae, ne se dilatent pas avec la croissance du parasite et restent normocytaires par rapport aux hématies non infectées. Ces caractéristiques sont utiles pour la différenciation en laboratoire des espèces de Plasmodium.
Après l'infection des hématies, un autre cycle de réplication asexuée a lieu. Initialement, une forme annulaire se développe, puis une différenciation en forme trophozoïte amiboïde se produit. Ensuite, un schizonte intra-érythrocytaire se développe, et il contient de nombreux mérozoïtes. Cette phase entraîne une amplification asexuée de l'organisme de 6 à 32 fois pour chaque hématie infectée. Le nombre de mérozoïtes produits dans le schizonte intra-érythrocytaire varie selon les espèces. Les schizontes observés sur le frottis sanguin sont utiles pour la détermination de l'espèce. Les parasites en développement métabolisent le glucose et utilisent l'hémoglobine des érythrocytes. L'utilisation parasitaire de l'hémoglobine produit le pigment caractéristique, l'hémozoïne, en tant que déchet.
Le cycle de reproduction asexuée érythrocytaire culmine avec la rupture des hématies. Les mérozoïtes sont libérés dans la circulation sanguine, et de nouveaux érythrocytes sont infectés. Ce cycle d'infection des érythrocytes, de réplication des mérozoïtes et de rupture des hématies est répétitif et peut devenir fortement synchronisé. Cette synchronisation est classiquement observée dans le paludisme tertiaire bénin causé par P. vivax. La rupture des érythrocytes et la libération des mérozoïtes se corrèlent aux symptômes cliniques du paludisme. Le cycle érythrocytaire de P. vivax et P. ovale survient toutes les 48 heures, tandis que celui de P. falciparum survient entre 36 et 48 heures. Le cycle érythrocytaire de P. malariae survient environ toutes les 72 heures.
Le mérozoïte infectant les érythrocytes peut aussi se différencier en gamétocyte micro- ou macrogamétocyte. Ces gamétocytes peuvent être ingérés par la femelle du moustique Anopheles lors d'un repas sanguin. La fusion des gamétocytes a lieu dans l'intestin du moustique. Le zygote diploïde mûrit et envahit la paroi intestinale. Une division méiotique s'ensuit, donnant naissance à des sporozoïtes haploïdes. Les sporozoïtes migrent vers les glandes salivaires du moustique pour compléter le cycle parasitaire.
| Caractéristique morphologique | P. falciparum | P. malariae | P. vivax/P. ovale |
|---|---|---|---|
| Taille des hématies infectées | Normocytaires | Normocytaires | Augmentée |
| Granulation des hématies | Points grossiers en forme de virgule parfois présents (points de Maurer) | Aucune | Fine granulation (points de Schuffner - P. vivax ; granulations de James - P. ovale) |
| Charge parasitaire | Souvent élevée | Souvent faible | Intermédiaire |
| > ; 1 organisme par cellule | Fréquent | Rare | Occasionnel |
| Formes en applique | Présentes | Généralement absentes | Généralement absentes |
| Présence de formes avancées | Généralement absente, sauf en cas de maladie sévère | Présentes | Présentes |
| Formes amiboïdes | Non applicable | Formes en panier, en bande et formes amiboïdes indistinctes | Formes indistinctes |
| Nombre de mérozoïtes par cellule | Non applicable | 6-12 (moyenne 8) | P. vivax : 12-24 (moyenne 16) ; P. ovale : 8-12 (moyenne 8) |
| Quantité de l'hématie occupée par le schizonte | Non applicable | Cellule entière | P. vivax : cellule entière ; P. ovale : occupe les deux tiers de la cellule |
| Gamétocyte distinctif " en forme de banane " | Présent | Absent | Absent |
| Cycle de la fièvre | Généralement sans cycle établi | Toutes les 72 heures | Toutes les 48 heures |
| Hypnozoïtes | Absents | Absents | Présents |
Remarques : La connaissance des espèces de Plasmodium endémiques dans la zone où le patient a contracté le paludisme est utile pour restreindre les possibilités diagnostiques. Dans les zones non endémiques, la rechute due aux hypnozoïtes de P. vivax ou P. ovale est souvent mise en évidence par une réactivation plusieurs mois après le départ d'une région endémique.
| Espèce | Schéma clinique typique |
|---|---|
| P. vivax/P. ovale | Épisodes cycliques constitués de frissons, suivis de fièvre, puis de défervescence et de diaphorèse ; cycles toutes les 48 heures. |
| P. malariae | Épisodes cycliques constitués de frissons, suivis de fièvre, puis de défervescence et de diaphorèse ; cycles toutes les 72 heures ; glomérulonéphrite à complexes immuns possible. |
| P. falciparum | Fièvres continues avec pics irréguliers ; hyperparasitémie possible avec lésions microvasculaires et défaillance. Il s'agit d'une urgence médicale chez la personne non immunisée. L'atteinte microvasculaire peut entraîner des lésions du système nerveux central, une insuffisance rénale et pulmonaire, et la mort. |
| Indication | Population | Type de schéma | Détails du schéma |
|---|---|---|---|
| Paludisme à P. falciparum provenant de zones avec résistance à la chloroquine | Enfants | Premier choix | Méfloquine, 25 mg/kg, sans dépasser la posologie adulte, PO, prise avec ≥ 237 mL (8 onces (oz)) d'eau (dose unique). |
| Paludisme à P. falciparum provenant de zones avec résistance à la chloroquine | Adultes | Premier choix | Méfloquine, cinq comprimés de 250 mg (1250 mg) PO, avec ≥ 237 mL (8 onces (oz)) d'eau (dose unique). |
| Paludisme à P. falciparum provenant de zones avec résistance à la chloroquine | Enfants | Deuxième choix | Sulfate de quinine, 25 mg/kg/j PO avec doxycycline3, 2 mg/kg/j pendant 7 jours, administrée avec la quinine ; ou suivie de pyriméthamine-sulfadoxine (0,25 comprimé : âge < ; 1 an ; 0,5 comprimé : âge 1-3 ans ; 1,0 comprimé : âge 4-8 ans ; 2 comprimés : âge 9-14 ans ; 3 comprimés : âge ≥ 15 ans) ; ou suivie de clindamycine, 20-40 mg/kg/j en 3 prises fractionnées. |
| Paludisme à P. falciparum provenant de zones avec résistance à la chloroquine | Adultes | Deuxième choix | Sulfate de quinine, 650 mg PO toutes les 8 h pendant 3-7 jours, avec l'une des options suivantes : doxycycline, 100 mg deux fois par jour pendant 7 jours ; ou suivie de 3 comprimés de pyriméthamine-sulfadoxine ; ou suivie de clindamycine, 900 mg trois fois par jour pendant 5 jours. |
| Paludisme à P. falciparum (sévère ; traitement parentéral) | Enfants | Traitement parentéral | Dichlorhydrate de quinine, 20 mg de sel/kg en dose de charge IV dans du dextrose à 5 % administrée sur 4 heures, suivie de 10 mg de sel/kg administrée sur 2-4 heures toutes les 8 h (dose maximale : 1800 mg/jour) ; ou gluconate de quinidine, 10 mg de sel/kg en dose de charge dans du sérum physiologique, avec perfusion lente sur 1-2 heures (dose maximale : 600 mg), suivie d'une perfusion continue à 0,02 mg/kg/min. |
| Paludisme à P. falciparum (sévère ; traitement parentéral) | Adultes | Traitement parentéral | Dichlorhydrate de quinine, 20 mg de sel/kg en dose de charge IV dans du dextrose à 5 % administrée sur 4 heures, suivie de 10 mg de sel/kg administrée sur 2-4 heures toutes les 8 h (dose maximale : 1800 mg/jour) ; ou gluconate de quinidine, 10 mg de sel/kg en dose de charge dans du sérum physiologique, avec perfusion lente sur 1-2 heures (dose maximale : 600 mg), suivie d'une perfusion continue à 0,02 mg/kg/min. |
| Paludisme causé par P. vivax, P. ovale, P. malariae et P. falciparum sensible à la chloroquine | Enfants | Premier choix | Chloroquine, 10 mg base/kg en dose de charge PO (sans dépasser 600 mg base), suivie de 5 mg base/kg (sans dépasser 300 mg base) administrée 6 heures après la première dose, puis de nouveau aux jours 2 et 3. |
| Paludisme causé par P. vivax, P. ovale, P. malariae et P. falciparum sensible à la chloroquine | Adultes | Premier choix | Chloroquine, 600 mg base (1000 mg chloroquine phosphate) PO en dose de charge, suivie de 300 mg base administrée 6 heures après la première dose, puis de nouveau aux jours 2 et 3. |
| Maladie latente causée par P. vivax/P. ovale | Enfants | Premier choix | Phosphate de primaquine, 0,3 mg base (0,5 mg sel)/kg/j pendant 14 jours. |
| Maladie latente causée par P. vivax/P. ovale | Adultes | Premier choix | Phosphate de primaquine, 15,3 mg base (26,5 mg sel) une fois par jour PO pendant 14 jours, ou 45 mg base (79 mg sel) une fois par semaine pendant 8 semaines. |
- Le paludisme falciparum sévère doit être traité par un traitement parentéral ; la méfloquine ne doit pas être utilisée pour le traitement du paludisme falciparum sévère, car il n'existe pas de formulation parentérale. Les options incluent la quinine (comme ci-dessus), la quinidine, l'artésunate et l'artéméther.
- La transfusion d'échange peut sauver la vie des patients non immunisés atteints de paludisme falciparum sévère et est indiquée si la parasitémie est > ; 30 % ou si la parasitémie est > ; 10 % et que des facteurs de mauvais pronostic sont présents (c.-à-d. : personnes âgées, schizontes dans le sang périphérique), en présence de manifestations systémiques sévères (c.-à-d. : paludisme cérébral, insuffisance pulmonaire ou rénale), ou en cas d'échec thérapeutique.
- Ne pas utiliser la doxycycline chez les femmes enceintes ni chez les enfants < ; 8 ans.
Les recommandations thérapeutiques et les schémas de résistance aux médicaments évoluent au fil du temps. Les schémas thérapeutiques du paludisme doivent toujours être sélectionnés et surveillés par des cliniciens familiers des recommandations actuelles ; les patients ne doivent pas tenter l'automédication.
| Catégorie | Mesure |
|---|---|
| Contrôle du vecteur | Éviter les zones infestées de moustiques. |
| Contrôle du vecteur | Porter des vêtements protecteurs pendant les heures du soir et de la nuit. |
| Contrôle du vecteur | Utiliser un répulsif anti-moustiques (contenant 30-35 % de DEET pour les adultes ou 6-10 % de DEET pour les enfants). |
| Contrôle du vecteur | Pulvériser les draps et les moustiquaires avec l'insecticide perméthrine. |
| Contrôle du vecteur | Sauf nécessité absolue, les femmes enceintes ne devraient pas voyager dans des zones endémiques de P. falciparum. |
| Mesures prophylactiques | La chloroquine reste le médicament de choix dans les zones sans résistance connue à la chloroquine. |
| Mesures prophylactiques | La méfloquine est utilisée dans les zones où des souches résistantes à la chloroquine sont connues. |
| Mesures prophylactiques | La doxycycline doit être utilisée lorsque la méfloquine ne peut pas être prise, sauf chez les femmes enceintes, les enfants < ; 8 ans ou les personnes présentant une hypersensibilité à la doxycycline. |
| Mesures prophylactiques | La chloroquine et le proguanil ne doivent être utilisés que chez les patients qui ne peuvent pas prendre de méfloquine ou de doxycycline. |
| Auto-traitement d'urgence du paludisme possible | Les personnes utilisant une prophylaxie par chloroquine dans des zones où des souches résistantes à la chloroquine peuvent être présentes doivent disposer d'une ou plusieurs doses thérapeutiques de Fansidar (25 mg pyrimethamine + 500 mg sulfadoxine/comprimé) (posologie adulte : 3 comprimés PO en dose unique ; posologie pédiatrique : 5-10 kg, 1/2 comprimé ; 11-20 kg, 1 comprimé ; 21-30 kg, 1 1/2 comprimés ; 31-45 kg, 2 comprimés ; > ; 45 kg, dose adulte). |
| Catégorie | Caractéristiques cliniques |
|---|---|
| Le plus fréquent | Asymptomatique. |
| Moins fréquent | Infection bénigne : myalgies, fièvre légère avec frissons, fatigue, nausées, céphalées. Infection sévère (plus fréquente chez les splénectomisés, les sujets âgés ou immunodéprimés) : anémie hémolytique (avec jaunisse et urines foncées), aggravation des symptômes ci-dessus. |
| Population | Type de schéma | Détails du schéma |
|---|---|---|
| Enfants | Premier choix | Clindamycine (20 mg/kg/j) pendant 7-10 jours, plus quinine (25 mg/kg/j PO) pendant 7-10 jours. |
| Adultes | Premier choix | Clindamycine (300-600 mg toutes les 6 h) plus quinine (650 mg PO toutes les 6-8 h) pendant 7-10 jours. |
Le traitement de la babésiose doit être guidé par des cliniciens expérimentés dans la prise en charge des infections parasitaires, car la gravité de la maladie et les facteurs liés à l'hôte peuvent influencer de manière significative les choix thérapeutiques.
| Catégorie | Mesure |
|---|---|
| Mesure prophylactique | Éviter les zones infestées de tiques. |
| Mesure prophylactique | Porter des vêtements appropriés et des répulsifs contre les tiques si l'évitement est impraticable. |
| Mesure prophylactique | Réaliser une inspection du corps et du cuir chevelu à la sortie des zones infestées. |

















